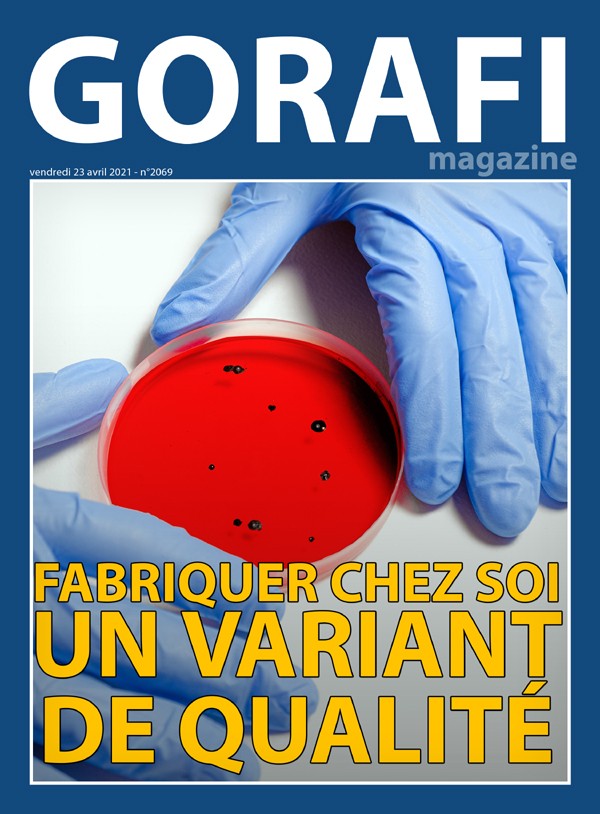

France
Gorafi Magazine : Fabriquer chez soi un variant de qualité
Le Gorafi lance son journal papier avec du contenu 100% inédit ! Cliquez ici pour le recevoir chez vous. C'est un must-have pour votre salon ou vos toilettes.
Continue Reading





